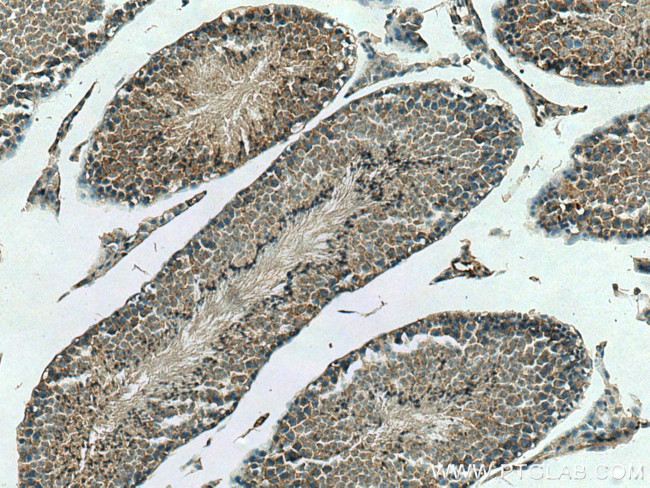
DCTN6 Antibody in Immunohistochemistry (Paraffin) (IHC (P))

Search
Proteintech
DCTN6 Polyclonal Antibody
{{$productOrderCtrl.translations['antibody.pdp.commerceCard.promotion.promotions']}}
{{$productOrderCtrl.translations['antibody.pdp.commerceCard.promotion.viewpromo']}}
{{$productOrderCtrl.translations['antibody.pdp.commerceCard.promotion.promocode']}}: {{promo.promoCode}} {{promo.promoTitle}} {{promo.promoDescription}}. {{$productOrderCtrl.translations['antibody.pdp.commerceCard.promotion.learnmore']}}
产品信息
16947-1-AP
种属反应
已发表种属
宿主/亚型
分类
类型
抗原
偶联物
形式
浓度
规格
纯化类型
保存液
内含物
保存条件
运输条件
产品详细信息
Immunogen sequence: MAEKTQKSV KIAPGAVVCV ESEIRGDVTI GPRTVIHPKA RIIAEAGPIV IGEGNLIEEQ ALIINAYPDN ITPDTEDPEP KPMIIGTNNV FEVGCYSQAM KMGDNNVIES KAYVGRNVIL TSGCIIGACC NLNTFEVIPE NTVIYGADCL RRVQTERPQP QTLQLDFLMK ILPNYHHLKK TMKGSSTPVK N (1-190 aa encoded by BC013175)
靶标信息
The protein encoded by this gene contains an RGD (Arg-Gly-Asp) motif in the N-terminal region, which confers adhesive properties to macromolecular proteins like fibronectin. It shares a high degree of sequence similarity with the mouse homolog, which has been suggested to play a role in mitochondrial biogenesis. The exact biological function of this gene is not known. [provided by RefSeq, Jul 2008]
仅用于科研。不用于诊断过程。未经明确授权不得转售。
生物信息学
蛋白别名: DCTN6; dynactin 6; Dynactin subunit 6; Dynactin subunit p27; novel RGD-containing protein; p27 dynactin subunit; Protein WS-3; RGD containing protein; unnamed protein product; WS-3
基因别名: AU044699; DCTN6; p27; WS-3; WS3
UniProt ID: (Human) O00399, (Mouse) Q9WUB4
Entrez Gene ID: (Human) 10671, (Mouse) 22428, (Rat) 290798